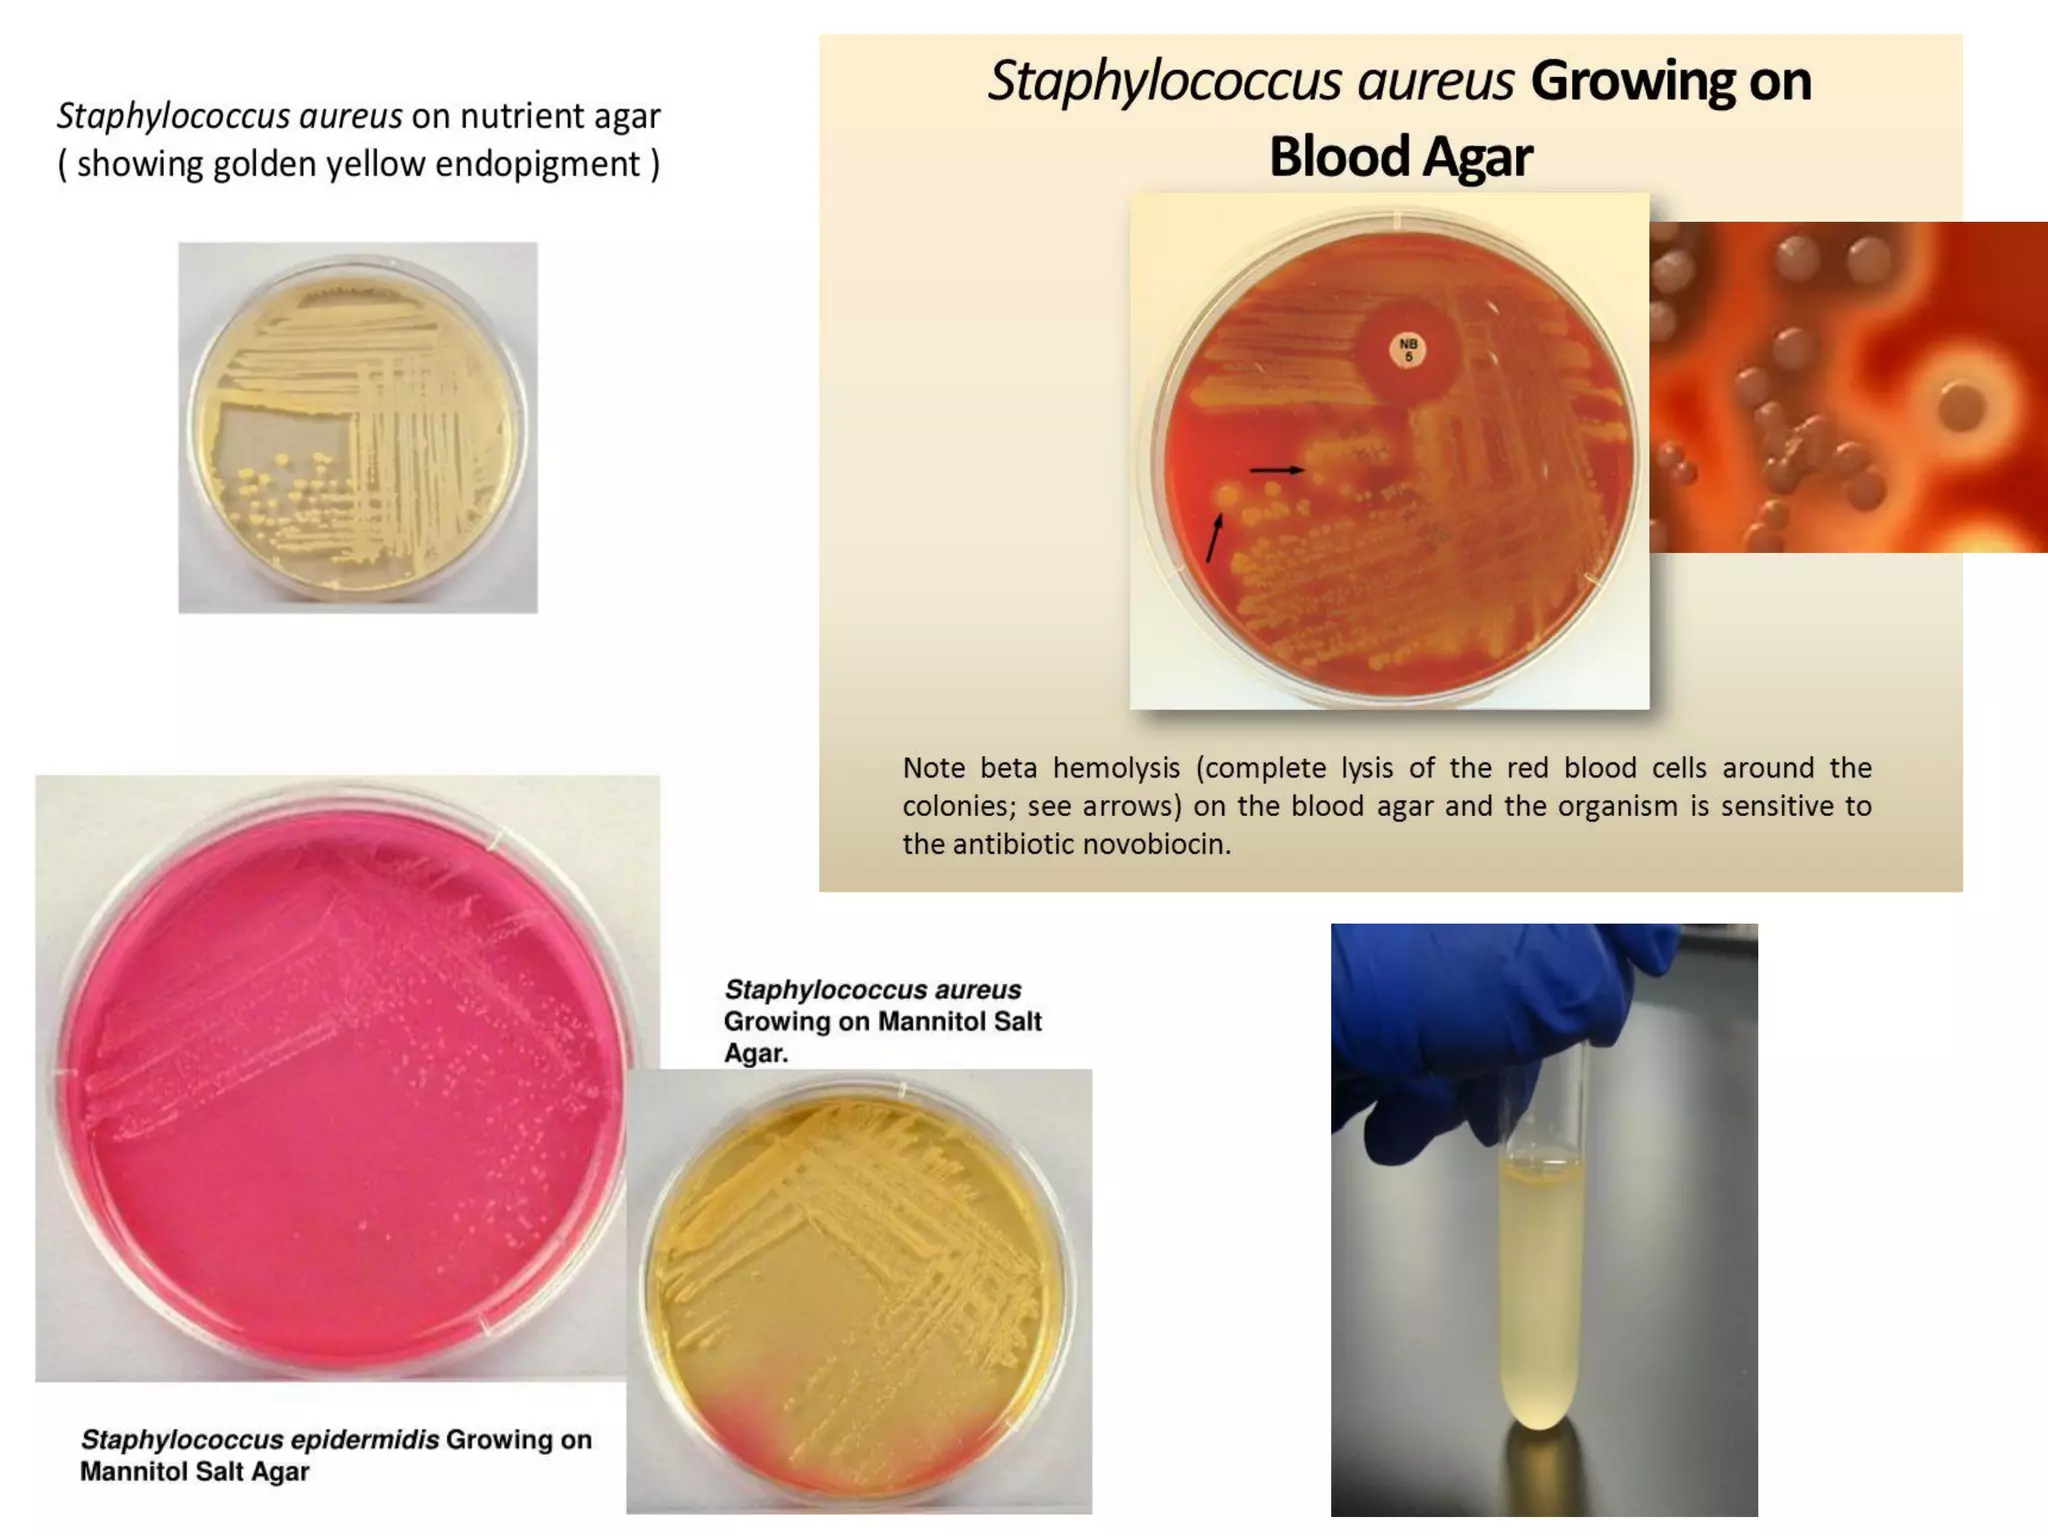

Staphylococcus are gram positive cocci that commonly colonize human skin and can cause infections. S. aureus is an important human pathogen capable of causing skin infections like impetigo as well as serious infections like pneumonia, meningitis, and toxic shock syndrome. Other pathogenic species include S. epidermidis and S. saprophyticus which can cause opportunistic infections in hospital settings and UTIs respectively. S. aureus is identified through its ability to ferment mannitol and coagulate plasma, while antibiotic resistance has become a major problem in treating staphylococcal infections.